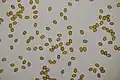
Sporen

Goudvliesbundelzwam
| Goudvliesbundelzwam[1] | |||||||||||||||
|---|---|---|---|---|---|---|---|---|---|---|---|---|---|---|---|

| |||||||||||||||
| Taxonomische indeling | |||||||||||||||
| |||||||||||||||
| Soort | |||||||||||||||
| Pholiota adiposa (Batsch) P.Kumm. (1871[2]) | |||||||||||||||
| Afbeeldingen op | |||||||||||||||
| |||||||||||||||
De goudvliesbundelzwam (Pholiota adiposa)[3][1][4], ook wel slijmsteelbundelzwam, is een schimmel die behoort tot de familie Strophariaceae. Hij is te vinden in bossen en parken. Hij groeit op loof- en naaldbomen, zowel levend als dood. Hij produceert vruchtlichamen van augustus tot oktober. Hij leeft voornamelijk op beuken, esdoorns, sparren, kastanjebomen en wilgen. Meestal groeien vruchtlichamen in bundels op grotere hoogte, vooral in de buurt van de holte van dode takken.
Kenmerken
Uiterlijke kenmerken
- Hoed
De hoed heeft een diameter van 5 tot 13 cm. Bij jonge vruchtlichamen is de vorm klokvormig, later convex en uiteindelijk plat. Bij jonge vruchtlichamen, en bij oudere, bij nat weer, is het oppervlak glanzend en zeer glad, zelfs vettig en heeft het een kleur van zwavelgeel tot citroengeel. Het is bedekt met vezelige, aangrenzende en grote schubben met een donkerdere, roestbruine kleur. Bij regen worden ze weggespoeld.
- Lamellen
De lamellen zijn dicht, breed en convergerend, aanvankelijk bleekgeel, daarna roestig.
- Steel
De steel heeft een lengte van 5 tot 12 cm en een dikte van 6 tot 15 mm[5]. Het is cilindrisch, erg glad, aanvankelijk vol en dan leeg van binnen. Het oppervlak is glad, met slechts enkele zwavelgele schubben en alleen een bruinachtige bodem. Het heeft een verdwijnende gelobde ring.
- Geur
Het vlees is geel. De smaak is mild en de geur ongedefinieerd.
- Sporenprint
De sporenprint is bruin.
Microscopische kenmerken
De basidia zijn 4-sporig, clavaat, hyaliene in KOH, zwak geelachtig in Melzers reagens en meten 16-20 × 3,5-5 µm. De gladde basidiosporen zijn ovaal tot elliptisch en meten afmeting 5-6 × 3-4 µm met een kleine apicale kiempore. In KOH is de kleur bleek. In Melzers reagens kleuren de sporen geel. Pleurocystidia zijn donkerbruin in KOH en in Melzers reagens en meten 25-40 × 5-10 µm. Chrysocystidia meten 18-28 (33) × 6-9 (13) µm.[5]
Verspreiding
De goudvliesbundelzwam komt voor in Noord-Amerika en Europa. In Nederland komt hij matig algemeen voor. Hij is niet bedreigd[1].
Foto's
-
Sporen
Sporen
- ↑ a b c NMV Verspreidingsatlas Paddenstoelen. Gearchiveerd op 26 oktober 2022.
- ↑ (en) Index Fungorum
- ↑ Volgens Holec (2001) of Noordeloos (2011) zijn Pholiota aurivella en Pholiota adiposa synoniem met elkaar. Dit inzicht wordt gesteund door Verspeidingsatlas, Soortenregister en Waarneming.nl, maar niet door Index Fungorum, Mycobank en GBIF
- ↑ Nederlands Soortenregister
- ↑ a b Pholiota adiposa op mykoweb.com. Gearchiveerd op 26 oktober 2022.